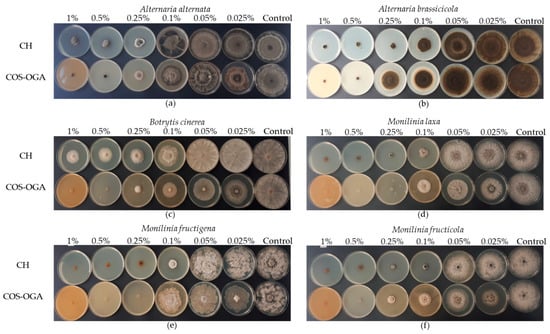

Abstract
Use of novel alternative compounds in agriculture is being promoted to reduce synthetic pesticides. An in vitro study was conducted to evaluate antimicrobial and antioxidant activities of chitosan hydrochloride (CH) and COS (chito-oligosaccharides)-OGA (oligo-galacturonides) at concentrations of 1%, 0.5%, 0.25%, 0.1%, 0.05%, and 0.025%. COS-OGA at 1% and 0.5% concentrations completely inhibited mycelial growth of Alternaria alternata, Alternaria brassicicola, Botrytis cinerea, Monilinia laxa, Monilinia fructigena, and Monilinia fructicola. Further, complete inhibition was observed with 0.25% COS-OGA for M. fructigena and M. laxa. Inhibition for B. cinerea, M. fructicola, A. alternata, and A. brassicicola at 0.25% COS-OGA was 86.75%, 76.31%, 69.73%, and 60.45%, respectively. M. laxa and M. fructigena were completely inhibited by CH concentrations of 1–0.25% and M. fructicola by concentrations of 1–0.5%. At CH 0.25%, inhibition for M. fructicola, A. brassicicola, A. alternata, and B. cinerea was 93.99%, 80.99%, 69.73%, and 57.23%, respectively. CH showed effective antibacterial activity against foodborne Escherichia coli. COS-OGA had higher antioxidant activity than CH when assessed by DPPH and hydroxyl radical scavenging assays. Our findings offer insights into the antimicrobial efficacy and mechanisms of action of these novel compounds, which have the potential to serve as alternatives to synthetic pesticides. In vivo investigations are required to validate the prospective application of these treatments for pre- and postharvest disease management.
1. Introduction
Food loss and waste (FLW) is an important global problem in primary production, processing, and retail industries and impacts household consumers. One-third of all food produced, equal to 1.3 billion tons, is lost or wasted every year, including approximately 50% of all fruits and vegetables, which is lost on farms and during storage [1,2]. According to the Food and Agriculture Organization of the United Nations (FAO), annual plant diseases cost the global economy around USD 220 billion [2]. Under the Farm to Fork strategy of the European Green Deal, the European Commission has committed to halving per capita food waste at the retail and consumer levels and reducing the use of dangerous synthetic pesticides by 50% by 2030 (SDG Target 12.3) [3]. The strict regulations on pesticide use (Directive 2009/128/CE) in agriculture due to consumer needs demand the development of techniques and strategies that can be utilized in production and processing industries to minimize FLW while contributing to improved food security and safety and the maintenance of environmental sustainability [4,5]. Fruits and vegetables have antimicrobial, anti-inflammatory, antiallergic, cytotoxic, and antioxidant properties that contribute to a balanced and healthy diet and lifestyle [6]; therefore, producers and consumers must strive to acquire quality fresh produce free of contaminants.
Microbial infections affect the appearance of products, thus reducing production yields and market quality, which contributes to FLW of fruits and vegetables [7]. The genus Alternaria consists of several pathotypes that cause diseases in a wide range of hosts, including cucurbits, tomatoes, peppers, and leafy crucifers [8]. Botrytis cinerea, the causal agent of gray mold, is considered one of the most important postharvest pathogens in fresh fruits and vegetables, causing economic losses of USD 10 billion annually [9,10]. Monilinia species cause brown rot, mainly Monilinia laxa, Monilinia fructigena, and Monilinia fructicola, and this disease is of economic importance in major stone fruit-producing areas worldwide as it is capable of causing losses of 80–85% post harvest [11,12]. The most virulent of these species is M. fructicola, which was introduced in Europe in 2001 [13] and has rapidly spread to other European countries, becoming more prevalent than the former indigenous species [14]. Fresh produce can also be contaminated by other microorganisms, such as bacteria, that can be dangerous to human health. For instance, the foodborne bacteria Escherichia coli has been associated with outbreaks attributed to the consumption of ready-to-eat salads and sauces prepared from fresh produce such as tomato, onion, lettuce, and spinach [15]. Furthermore, microbial contaminants produce mycotoxins in infected crops, which can be harmful to humans when ingested [16].
In the preharvest stage, disease prevention is usually achieved through sanitation practices aimed at reducing inoculum sources in the field in conjunction with other practices, such as foliar application of plant protection products [17,18]. Fruits and vegetables also undergo chemical washing treatments at the postharvest stage to improve shelf life; these treatments could result in the generation of hazardous by-products [19,20]. Moreover, the development of resistance to agricultural products and antibiotics by fungi [21] and bacteria [22], respectively, is a pressing concern within the scientific community. The use of novel alternative strategies such as elicitors is crucial for ensuring agricultural sustainability. Elicitors are substances or agents that can induce a response in plants; they offer many advantages in agriculture since they are non-toxic to humans and non-target organisms [23]. One such well-known elicitor is chitosan, a biodegradable natural biopolymer obtained from crustaceans, insects, and fungi with elicitation, antimicrobial, and film-forming properties [24,25,26,27,28,29] that are attributed to its structural and physicochemical properties [30]. In agriculture, many chitosan-based products are currently available for commercial use both in the pre- and postharvest stages [24]. For example, chitosan hydrochloride (CH) is a basic substance, approved in 2014 (Reg. EU 563/2014), that has fungicidal, bactericidal, and plant defense elicitation properties [31]. COS (chito-oligosaccharides)-OGA (oligo-galacturonides; COS-OGA) is a novel compound resulting from the combination of chitosan oligosaccharide with pectin-derived OGA originating from plant cell walls. This complex was recognized as an elicitor able to activate plant defense responses and consequently mediate pathogenesis [32,33,34,35,36]. Žabka et al. [27] reported the effectiveness of CH in controlling Phytophthora infestans. Research findings by van Aubel et al. [33] indicate that COS-OGA is effective in triggering defense mechanisms in grapes and cucumbers, enhancing their resistance to fungal disease. Furthermore, elicitation of plant immunity by COS-OGA is a cumulative process involving the activation of salicylic acid, a key signaling molecule in plant defense mechanisms [34]. Moreover, COS-OGA is a low-risk active substance authorized in Europe under EU Regulation 543/2015 [37], and since 2016, its use has been permitted in organic farming in line with Council Regulation (EC) No. 834/2007 [38]. In the literature, there are many works reporting the antimicrobial effectiveness of both CH and COS-OGA, but there are a lack of data comparing the two compounds simultaneously against the microbial pathogens we studied in this current work. Therefore, the objectives of this study were (1) to evaluate the antimicrobial activities of CH and COS-OGA against six fungal and one bacterial species, (2) to determine the mode of action of the two compounds against the fungal pathogens, and (3) to determine the antioxidant activity of CH and COS-OGA.
2. Materials and Methods
2.1. Fungal Pathogens
The fungal pathogens used in this study were obtained from two known locations (Table 1). Each fungal species was replicated on potato dextrose agar (PDA; 40 g L−1; Liofilchem Srl, Roseto degli Abruzzi, Italy) in Petri dishes (diameter, 90 mm). All plates were incubated at 23 ± 1 °C, and pure cultures were obtained.

Table 1.
Details of fungal species used in this study.
2.2. In Vitro Antifungal Activities on Mycelial Growth
The antifungal activities of chitosan hydrochloride (CH, 100%; Agrilaete Srl, Palmanova (UD), Italy) and COS (chito-oligosaccharides)-OGA (oligo-galacturonides) (COS-OGA, 1.25%; Gowan Italia Srl, Faenza (RA), Italy) were evaluated by comparing equivalent concentrations of chitosan and monitoring the mycelia growth rate of A. alternata, A. brassicicola, B. cinerea, M. laxa, M. fructigena, and M. fructicola on Petri dishes with reference to the control according to Moumni et al. [39] with some modifications. Briefly, CH and COS-OGA at 1%, 0.5%, 0.25%, 0.1%, 0.05%, and 0.025% active ingredient concentrations were prepared in 250 mL of sterilized distilled water. The PDA and compound mixtures with different treatments were homogenized using a rotator (FALC Instruments Srl, Treviglio (BG), Italy) to obtain a final volume of 500 mL, which was immediately poured into Petri dishes (diameter, 90 mm; 20 mL/plate). Plates with PDA alone (20 g of PDA in 500 mL of sterilized distilled water) were used as the untreated control. Mycelia plugs (7 mm) of each fungus were taken from 7–10-day old plates and placed in the center of the amended Petri dishes. The experiments were performed in five replicates per concentration per treatment. The orthogonal diameters of the colonies were measured daily; the first measurement was carried out two days post-inoculation, until the control plates were completely covered by mycelia. Mycelial growth inhibition was calculated using Equation (1):
where dc and dt represent the mean diameter of mycelial growth in the control and treated fungal strains, respectively.
Mycelial growth inhibition (%) = [(dc − dt)/dc] × 100
2.3. Fungicidal and Fungistatic Activities of CH and COS-OGA
Select treatments with complete inhibition of mycelial growth were subjected to a further assay to determine if they had fungicidal or fungistatic activities on the fungal pathogens according to Moumni et al. [39]. Mycelial plugs were transferred to fresh unamended PDA and incubated at 20 ± 1 °C for 7 days, after which the presence or absence of mycelia was assessed. Treatments were classified as either fungicidal or fungistatic based on the absence or presence of mycelial growth.
2.4. Antibacterial Activity of CH
The antibacterial activity of CH particles was evaluated against Escherichia coli according to Huang et al. [40]. In each test, 100 mL Erlenmeyer flasks containing 50 mL of tryptone soy broth (17.0 gL−1 tryptone, 3.0 gL−1 soytone, 2.5 gL−1 dextrose, 5.0 gL−1 sodium chloride, 2.5 gL−1 dipotassium phosphate) were used. Culture flasks were inoculated using a fresh culture of E. coli and preliminarily adjusted to a concentration of 1.0 × 106 CFU/mL. A fixed amount of chitosan (10 mg/mL) was then added to the flask. The culture was shaken at 150 rpm using a magnetic stirrer and was maintained at 37 °C. After a 24 h growth cycle, serial dilutions (from 10−1 to 10−7) were performed, and 1 mL of each sample was used to inoculate the agar plates. Subsequently, the culture was spread and incubated for 24 h at 37 °C in an oven at a controlled temperature, and the number of vital bacteria was determined as CFU/mL.
2.5. In Vitro Antioxidant Activity by DPPH Radical Scavenging Ability Assay
1-Diphenyl-2-picrylhydrazyl (DPPH) radical scavenging activity (RSA) was assayed according to the method described by Hu et al. [41]. CH and COS-OGA were dissolved in acidified water at pH 2.5, obtaining concentrations ranging from 0.05 to 30 mg/mL, and analyzed to evaluate antioxidant activity. Briefly, 200 µL of 0.4 mM DPPH solution in methanol was mixed with 50 µL of each sample in a 96-well microplate. The mixture was shaken vigorously and maintained in the dark at room temperature for 30 min. Finally, the absorbance was measured at 517 nm and the inhibition of DPPH was determined by evaluating the color change in the wells (violet → yellow). DPPH inhibition values were calculated using Equation (2):
where Acontrol and Asample are the absorbance values of DPPH after the addition of 50 µL of pure water or 50 µL of CH and COS-OGA solutions, respectively.
2.6. In Vitro Antioxidant Activity by Hydroxyl Radical Scavenging Ability Assay
The test of hydroxyl radical scavenging ability was also carried out according to the method of Hu et al. [41]. The reaction mixture containing testing samples was incubated with EDTA-Fe2+ (220 µmol/L), safranine T (0.23 µmol/L), and H2O2 (60 µmol/L) in potassium phosphate buffer (150 mM, pH 7.4) for 30 min at 37 °C. Successively, the absorbance was measured at 520 nm. The scavenging effect was calculated according to Equation (3):
where Asample 520 nm is the absorbance of the sample at 520 nm; Acontrol 520 nm is the absorbance of the control (distilled water instead of H2O2) at 520 nm; and Ablank 520 nm is the absorbance of the blank (distilled water instead of samples) at 520 nm.
2.7. Statistical Analysis
All trials were conducted in replicates of five, and the data are expressed as mean ± standard deviation (SD). Using SPSS (version 21.0, SPSS Inc.; Chicago, IL, USA), the Shapiro-Wilk’s test (p ≤ 0.05) was performed to verify the residual assumption of normality, and Levene’s test was employed to assess the homogeneity of variance between treatments for all fungal pathogens. Variances in the treatments were not homogenous for all fungal pathogens studied. Thus, the data were subjected to Welch analysis of variance (ANOVA) and means were separated using the Games–Howell test at p ≤ 0.05. The ‘heatmaply’ package was used to prepare the fungal mycelia growth heatmap figure with RStudio version 2023.03.0+386. The SPSS software was also used to carry out statistical analysis of antibacterial activity against Escherichia coli. A t-test was carried out to compare bacterial growth in the presence and in the absence of chitosan. p values lower than 0.05 (p < 0.05) were considered significant.
3. Results
3.1. In Vitro Inhibition of Fungal Growth
All treatments were able to reduce the mycelial growth of all fungal species tested when compared to the untreated PDA control, except for CH at 0.05% and 0.025% concentrations (Figure 1; Table 2). CH at these concentrations showed mycelial growth inhibition ranging from 0.48% to 19.70% for all the pathogens. For COS-OGA at concentrations of 0.05% and 0.025%, inhibition ranged between 10.23% and 41.16%. The other concentrations tested for both compounds showed varying levels of effectiveness against fungal pathogens in a dose-dependent manner compared with the untreated control (Table 2). CH treatments at 1%, 0.5%, and 0.25% concentrations were highly effective and completely inhibited the mycelial growth of M. laxa and M. fructigena, whereas complete inhibition of M. fructicola was observed at concentrations of 1% and 0.5%. For COS-OGA treatment at 1% and 0.5% concentrations, total mycelial growth inhibition was achieved for all the species used in the study. Additionally, there were no significant differences between 1%, 0.5%, and 0.25% CH treatments against A. brassicicola and A. alternata; mycelial growth inhibition of the two species was 85.49% and 74.82% at 1%, 83.56% and 73.97% at 0.5%, and 83.44% and 69.73% at 0.25% CH. At the same three concentrations, inhibition of B. cinerea was 66.75%, 61.08, and 57.23%, respectively. In comparison, the mycelial growth of M. laxa and M. fructigena was completely inhibited by COS-OGA at 0.25% concentration. The same treatment inhibited the mycelial growth of B. cinerea, M. fructicola, A. alternata, and A. brassicicola by 86.75%, 76.31%, 69.73%, and 55.24%, respectively. Moreover, the CH 0.1% treatment inhibited mycelial growth by 78.86%, 73.77%, 67.69%, 59.24%, 40.48%, and 21.17% against M. laxa, M. fructicola, M. fructigena, A. brassicicola, B. cinerea, and A. alternata, respectively. The 0.1% COS-OGA treatment inhibited the mycelial growth of M. laxa, M. fructicola, B. cinerea, A. brassicicola, M. fructigena, and A. alternata by 56.62%, 52.98%, 52.29%, 38.66%, 35.78%, and 27.32%, respectively. Furthermore, the 0.05% CH treatment promoted the overgrowth of M. fructigena (−4.85%).
Figure 1.
Representative experiment showing the mycelial growth of (a) Alternaria alternata, (b) Alternaria brassicicola, (c) Botrytis cinerea, (d) Monilinia laxa, (e) Monilinia fructigena, and (f) Monilinia fructicola treated with chitosan hydrochloride (CH; 100%) and COS (chito-oligosaccharides)-OGA (oligo-galacturonides) (COS-OGA; 1.25%) at 1%, 0.5%, 0.25%, 0.1%, 0.05%, and 0.025% in comparison to the untreated control after 5–17 days post-incubation at 20 ± 1 °C.

Table 2.
Mycelia growth (cm) of Alternaria alternata, Alternaria brassicicola, Botrytis cinerea, Monilinia laxa, Monilinia fructigena, and Monilinia fructicola treated with chitosan hydrochloride and COS (chito-oligosaccharides)-OGA (oligo-galacturonides) after 5–17 days post-incubation at 20 ± 1 °C.
An antifungal activity heatmap of CH and COS-OGA is shown in Figure 2. Both the fungal species and treatment concentrations used in this study are separated into two clusters each on the dendrogram. In brief, there are two clusters for the fungal species, one for Monilinia spp. and the other including A. alternata, A. brassicicola, and B. cinerea. Additionally, COS-OGA and CH at 1% to 0.25% concentrations were clustered on one side with observably higher inhibition for Monilinia spp. compared to Alternaria spp. and B. cinerea, which were less sensitive to both treatments. COS-OGA and CH 0.1% to 0.025% concentrations were clustered separately from the previous concentrations where there was variability in inhibition. CH 0.025% and 0.05% had the lowest efficacy, like that of the untreated control. Overall, there were significant differences between COS-OGA and CH treatments, with COS-OGA being the better treatment that achieved complete mycelial growth inhibition for all the fungal pathogens at 1% concentration.

Figure 2.
Heatmap of the mycelia growth (cm) of Monilinia fructigena, Monilinia laxa, Monilinia fructicola, Alternaria brassicicola, Alternaria alternata, and Botrytis cinerea treated with chitosan hydrochloride (CH) and COS (chito-oligosaccharides)-OGA (oligo-galacturonides; COS-OGA) after 5–17 days post-inoculation. The treatments listed on the left correspond to a different color on the right. Euclidean distance measurements were used to calculate the distances of the dendrogram and clusters using the ‘heatmaply’ package in RStudio.
3.2. Fungicidal and Fungistatic Activity of CH and COS-OGA
The fungicidal or fungistatic activity of CH and COS-OGA was dependent on the product (chitosan) formulation, fungal species, and, to a lesser extent, the treatment concentrations tested in the study. COS-OGA had a fungicidal effect against all fungal pathogens used in the study at 1% and 0.5% concentration, except for M. fructicola, which was fungistatic at 0.5% concentration (Table 3). Furthermore, at 0.25% concentration, COS-OGA had a fungicidal effect on M. laxa and M. fructigena. CH at 1% and 0.5% concentration had a fungistatic effect against M. laxa, M. fructigena, and M. fructicola, and additionally had an effect at 0.25% concentration against M. fructigena.

Table 3.
Fungicidal and fungistatic activities of chitosan hydrochloride and COS (chito-oligosaccharides)-OGA (oligo-galacturonides) against Alternaria alternata, Alternaria brassicicola, Botrytis cinerea, Monilinia laxa, Monilinia fructigena, and Monilinia fructicola after 7 days of incubation at 20 ± 1 °C.
3.3. Antibacterial Activity of Chitosan Hydrochloride
The antibacterial effect of CH was tested against E. coli with and without exposure to sunlight. The results are shown in Table 4 in terms of mean and standard deviation. In the presence of CH, the growth of E. coli was reduced significantly both in the dark and in sunlight to 4.9 log CFU/mL and 5.0 log CFU/mL, respectively. While in the absence of CH, the growth of E. coli was high in both conditions.

Table 4.
Antibacterial activity of chitosan hydrochloride (100%).
3.4. In Vitro Antioxidant Activity Assessed by DPPH and Hydroxyl Radical Scavenging Ability Assays
The antioxidant activity of CH and COS-OGA was evaluated by DPPH and hydroxyl radical scavenging assays in vitro. COS-OGA exhibited significantly high antioxidant activity of 22.1% compared to CH (5.3%) at the 20 mg/mL concentration (Table 5). Higher antioxidant activity of 29.9% was achieved when the COS-OGA concentration was increased to 30 mg/mL.

Table 5.
In vitro antioxidant activity as assessed by the DPPH and hydroxyl radical scavenging assay.
4. Discussion
In recent years, it has become imperative to limit the use of synthetic pesticides in agriculture. In the present study, we evaluated the antimicrobial activity of CH and COS-OGA in terms of their inhibitory effect against selected microorganisms that cause disease in crops at preharvest and postharvest stages. The in vitro study showed that COS-OGA was the most effective at inhibiting the mycelial growth of fungi. Mycelial growth of A. alternata, A. brassicicola, B. cinerea, M. laxa, M. fructigena, and M. fructicola was completely inhibited at concentrations of 1% and 0.5% COS-OGA, whereas for CH concentrations of 1% and 0.5%, complete inhibition was achieved for Monilinia spp. only, with the same result obtained for M. laxa and M. fructigena with COS-OGA and CH at 0.25% concentration.
Previous works reported that COS-OGA acts as a preventative elicitor of natural plant defense systems reducing the risk of resistance development by microorganisms since it mainly acts on the plant, and these studies demonstrated that COS-OGA can be applied repeatedly to achieve an accumulative elicitation effect against powdery mildew in table grapes and strawberries without incurring any negative effects [42]. COS-OGA treatments in tomato affected gene transcripts linked to defense mechanisms without phytotoxic effects on plants [35]. In our work, we establish that the COS-OGA compound not only acts as an elicitor of natural plant defense systems, but also strongly inhibits fungal growth. This assigns a synergistic action to this compound towards the control of plant diseases.
The highest concentrations tested in this work, 1% and 0.5%, correspond to the most common chitosan concentrations that have been tested in the control of preharvest and postharvest decay [24]. Rajestary et al. [30] reported that the optimal antifungal activity of chitosan against numerous microorganisms can be achieved at a concentration of 1%. Other studies reported complete inhibition of B. cinerea spore germination using an oligochitosan concentration of 0.5% (5 gL−1) [43], while low molecular weight (LMW) chitosan and oligochitosan (LCOC) at 0.05% and 0.01% significantly inhibited the conidia germination of A. brassicicola [44]. To the best of our knowledge, our work provides, for the first time, results related to the antimicrobial effectiveness of several concentrations of both COS-OGA and CH as tested on six different fungal pathogens.
Our results underline that the effectiveness of antimicrobial activity was affected by the type of target microorganism. This was true for the CH compound, while for COS-OGA at lower concentrations starting from 0.25%, we have evidence of variability amongst the fungal pathogens. As reported in previous works, the antimicrobial properties of chitosan are affected by many factors, including microorganisms and the physicochemical characteristics of the chitosan compound, such as molecular weight [45]. This point could be clarified by studying how different treatments affect the way fungal cells respond to stress [46].
Our study established that in vitro efficacy decreased in a different manner at decreasing doses of CH and COS-OGA compounds, highlighting differences among the fungal pathogens. A different inhibition of fungal growth was observed between the Monilinia spp. at the 0.25% concentration. Complete inhibition was achieved only for M. laxa and M. fructigena, while the mycelial growth of M. fructicola was only significantly reduced. A recent whole-genome analysis revealed various elements of phylogenomic and syntenic results, as well as pathogenic factors, suggesting that M. laxa is more closely related to M. fructigena than M. fructicola [47]. M. fructicola is considered the most virulent species as it is able to cause larger fruit lesions and displays shorter incubation and latency periods compared to the other Monilinia spp. [48]. Overall, inhibition of Monilinia spp. was different from the other fungal pathogens under study. This indicates that Monilinia spp. have the same mycelial growth inhibition pattern, which is different from the pattern of A. alternata, A. brassicicola, and B. cinerea.
Our in vitro study reflects the importance of in vitro tests to screen the best concentration–compound combination for possible implementation in in vivo studies. Previous studies reported the concentration-dependent inhibitory effectiveness of chitosan and oligochitosan on the mycelial growth and spore germination of M. fructicola [49]. Additionally, in vivo postharvest studies evidenced that the control of brown rot caused by M. fructicola was higher at a concentration of 0.5% compared to that of 0.05% [50]. We observed a decrease in mycelial growth inhibition relative to the reduced concentration of the compounds. Furthermore, a drastic decline in effectiveness was observed for concentrations of 0.05% and 0.025%, especially for CH, which did not differ compared to the untreated control. Differences between fungal species and compound efficacy were most noticeable at concentrations of 0.1% and lower. Thus, this indicates that efficacy against mycelia development was once more documented below a specific threshold, though their use in vivo could be limited by the unpredictable nature of the pathogen–compound interactions.
In this work, we also analyzed the differences related to the antifungal mode of action of these compounds. Our results suggested a direct fungicidal effect by COS-OGA, while CH had a fungistatic effect against the phytopathogenic fungi used in the study. To the best of our knowledge, this is the first study that demonstrates the fungicidal effect of COS-OGA. Our results corroborate those of Ali et al. [51], who reported the fungistatic effect of chitosan against Colletotrichum gloeosporioides. Although the fungicidal effect can be considered more attractive since it yields total suppression of fungal pathogens, the in vivo mode of action of these compounds could be affected by several factors, such as inoculum, titer, exposure time, application methods, and employed dose [52].
The in vitro antibacterial activity of CH in this study showed that the growth of foodborne Escherichia coli was significantly reduced to 4.9 log CFU/mL in dark conditions compared to light. This is in line with results by Tikhonov et al. [53]. Tsai et al. [54] reported that the antibacterial effect of chitosan against E. coli was also dependent on temperature. Furthermore, according to Mirbagheri et al. [55], chitosan, as well as its nanoparticle and alkylated derivative forms, has the potential to act as an antibacterial agent against E. coli by inhibiting outer membrane biosynthesis, metabolic activities, and membrane-related signaling pathways. In our study, CH had a significant inhibitory effect on the growth of E. coli in a light-deprived environment. These findings suggest that fresh produce treated with CH should have decreased bacterial contamination-related deterioration incidence during storage and transit, which often take place under controlled light and temperature conditions.
We also evaluated the in vitro antioxidant activity of CH with a molecular weight of 47 kDa to 65 kDa [56] and high molecular weight (HMW) COS-OGA [57]. Our DPPH and hydroxyl radical scavenging results showed that COS-OGA had a significantly high antioxidant activity of 29.9% compared to CH. Wan et al. [58] found that HMW chitosan and its LMW derivatives all possessed antioxidant activity; however, LMW chitosan derivatives exhibited higher DPPH scavenging activity. This is further supported by results reported by Xuan Du et al. [59]. Numerous studies have shown that chitosan and its derivatives, for instance COS-OGA, can enhance the antioxidant activity of plants when used as a plant protectant in singular or combined form [25,41,60]. Thus, these compounds can improve the defense mechanisms of plants against abiotic stress when applied at the preharvest stage.
The possible applications of elicitors in agriculture are vast, whether applied alone or in combination with other natural substances at preharvest and/or postharvest stages. Both CH and COS-OGA are natural biodegradable elicitors and thus can be used in the postharvest stage, as storage treatments or edible coatings, to manage decay and extend the shelf life of fresh fruits and vegetables without causing any harmful effects to the produce or consumers [61]. Research conducted in the last several years has demonstrated the effectiveness of chitosan when used alone or in combination with other natural ingredients to preserve the physical characteristics of different fruits and vegetables. Chitosan is known for its biocompatibility, biodegradability, and bioactivity; thus, when used as an edible coating, the film reduces the respiration rate of the produce by adjusting the permeability of oxygen consumption and carbon dioxide production, thereby extending its shelf life [61]. Additionally, there is no risk of developing resistance to these substances since elicitors focus on plant defense systems, such as inducing the accumulation of defense compounds and delaying fruit senescence to preserve fruits and vegetables, unlike chemical pesticides whose mode of action is on the pathogen itself [33,42,53].
5. Conclusions
The discovery and validation of effective alternative compounds to existing synthetic pesticides for the management of microbial organisms is crucial. Chitosan and its derivatives have been shown to possess substantial antimicrobial efficacy against various microorganisms. Consequently, we evaluated the antimicrobial efficacy of a pure form of CH and COS-OGA (a derivative) at varying concentrations against six fungal pathogens and one bacterial pathogen in vitro. The results demonstrated that CH and COS-OGA have an effect against microbial pathogens. Inhibitory effects against the fungal pathogens were especially significant at 1%–0.25% concentrations, while the growth of E. coli was noticeably reduced in the absence of light by CH. COS-OGA and CH also demonstrated valuable antioxidant capacity. Additionally, since these compounds have a direct impact on plants, the risk of resistance development by microbial organisms is limited. This study suggests that these innovative compounds could be used as alternatives to synthetic pesticides in plant disease management while preserving the agricultural environment and maintaining the health and safety of all parties. Moreover, as both CH and COS-OGA are derived from long-established, naturally occurring sources, the confirmation of their antimicrobial properties and antioxidant capacity offers the potential to repurpose waste generated during production. Our in vitro findings provide the foundation for subsequent in vivo investigations aimed at confirming the viability of using these two novel elicitors in pre- and postharvest management strategies.
Author Contributions
Conceptualization, G.R.; methodology, S.M.M., M.M., D.P., F.S. and G.R.; software, S.M.M. and M.M.; validation, L.L., F.S. and M.M.; formal analysis, S.M.M. and M.M.; investigation, S.M.M., D.P. and F.S.; resources, S.M.M., D.P. and F.S.; data curation, S.M.M. and M.M.; writing—original draft preparation, S.M.M., D.P. and F.S.; writing—review and editing, S.M.M., M.M., L.L., D.P., F.S. and G.R.; visualization, S.M.M. and G.R.; supervision, G.R.; project administration, G.R.; funding acquisition, G.R. All authors have read and agreed to the published version of the manuscript.
Funding
This work was conducted within PRIMA StopMedWaste ‘‘Innovative Sustainable technologies TO extend the shelf-life of Perishable MEDiterranean fresh fruit, vegetables and aromatic plants and to reduce WASTE”, which is funded by Partnership for Research and Innovation in the Mediterranean Area (PRIMA) Project ID 1556, a program supported by the European Union and the EUPHRESCO “Basic substances as an environmentally friendly alternative to synthetic pesticides for plant protection (BasicS)” project (Objective 2020-C-353). This study was also carried out within the Agritech National Research Center and received funding from the European Union Next-GenerationEU (PIANO NAZIONALE DI RIPRESA E RESILIENZA (PNRR)—MISSIONE 4 COMPONENTE 2, INVESTIMENTO 1.4—D.D. 1032 17/06/2022, CN00000022). This manuscript reflects only the authors’ views and opinions; neither the European Union nor the European Commission can be considered responsible for them.
Data Availability Statement
The data presented in this study are available on request from the corresponding author.
Acknowledgments
The authors would like to thank the Gaudioso Donation for the project “Research activities in the field of social agriculture for the employment inclusion of people with intellectual disabilities”, that supported the PhD fellowship of Sarah Mojela Makau.
Conflicts of Interest
The authors declare no conflict of interest.
References
- Jones, R.E.; Speight, R.E.; Blinco, J.L.; O’Hara, I.M. Biorefining within food loss and waste frameworks: A review. Renew. Sustain. Energy Rev. 2022, 154, 111781. [Google Scholar] [CrossRef]
- FAO. Fruit and Vegetables—Your Dietary Essentials. Available online: https://doi.org/10.4060/cb2395en (accessed on 23 October 2023).
- European Commission. Farm to Fork Strategy: For a Fair, Healthy, and Environmentally Friendly Food System. Available online: https://ec.europa.eu/food/system/files/2020-05/f2f_action-plan_2020_strategy-info_en.pdf (accessed on 19 January 2022).
- Chèze, B.; David, M.; Martinet, V. Understanding farmers’ reluctance to reduce pesticide use: A choice experiment. Ecol. Econ. 2020, 167, 106349. [Google Scholar] [CrossRef]
- Prusky, D.; Romanazzi, G. Induced resistance in fruit and vegetables: A host physiological response limiting postharvest disease development. Annu. Rev. Phytopathol. 2023, 61, 279–300. [Google Scholar] [CrossRef] [PubMed]
- Alegbeleye, O.; Odeyemi, O.A.; Strateva, M.; Stratev, D. Microbial spoilage of vegetables, fruits and cereals. Appl. Food Res. 2022, 2, 100122. [Google Scholar] [CrossRef]
- Yahaya, S.M.; Mardiyya, A.Y. Review of post-harvest losses of fruits and vegetables. Biomed. J. Sci. Tech. Res. 2019, 13, 10192–10200. [Google Scholar] [CrossRef]
- Woudenberg, J.H.C.; Seidl, M.F.; Groenewald, J.Z.; De Vries, M.; Stielow, J.B.; Thomma, B.P.H.J.; Crous, P.W. Alternaria section Alternaria: Species, formae speciales or pathotypes? Stud. Mycol. 2015, 82, 1–21. [Google Scholar] [CrossRef]
- Petrasch, S.; Knapp, S.J.; Van Kan, J.A.; Blanco-Ulate, B. Grey mould of strawberry, a devastating disease caused by the ubiquitous necrotrophic fungal pathogen Botrytis cinerea. Mol. Plant Pathol. 2019, 20, 877–892. [Google Scholar] [CrossRef]
- Williamson, B.; Tudzynski, B.; Tudzynski, P.; van Kan, J.A. Botrytis cinerea: The cause of grey mould disease. Mol. Plant Pathol. 2007, 8, 561–580. [Google Scholar] [CrossRef]
- Abate, D.; Pastore, C.; Gerin, D.; De Miccolis Angelini, R.M.; Rotolo, C.; Pollastro, S.; Faretra, F. Characterization of Monilinia spp. populations on stone fruit in South Italy. Plant Dis. 2018, 102, 1708–1717. [Google Scholar] [CrossRef]
- Mustafa, M.H.; Bassi, D.; Corre, M.N.; Lino, L.O.; Signoret, V.; Quilot-Turion, B.; Cirilli, M. Phenotyping brown rot susceptibility in stone fruit: A literature review with emphasis on peach. Horticulturae 2021, 7, 115. [Google Scholar] [CrossRef]
- Lichou, J.; Mandrin, J.F.; Breniaux, D.; Mercier, V.; Giauque, P.; Desbrus, D.; Blanc, P.; Belluau, E. Une nouvelle moniliose: Monilia fructicolas’ attaque aux arbres fruitiers à noyaux. Phytoma 2002, 547, 22–25. [Google Scholar]
- Villarino, M.; Egüen, B.; Melgarejo, P.; Lamarca, N.; Segarra, J.; Usall, J.; Melgarejo, P.; de Cal, A. Occurrence of Monilinia laxa and M. fructigena after introduction of M. fructicola in peach orchards in Spain. Eur. J. Plant Pathol. 2013, 137, 835–845. [Google Scholar] [CrossRef]
- Luna-Guevara, J.J.; Arenas-Hernandez, M.M.; Martínez de la Peña, C.; Silva, J.L.; Luna-Guevara, M.L. The role of pathogenic E. coli in fresh vegetables: Behavior, contamination factors, and preventive measures. Int. J. Microbiol. 2019, 2019, 2894328. [Google Scholar] [CrossRef]
- Slavin, J.L.; Lloyd, B. Health benefits of fruits and vegetables. Adv. Nutr. 2012, 3, 506–516. [Google Scholar] [CrossRef] [PubMed]
- Suriyaprom, S.; Mosoni, P.; Leroy, S.; Kaewkod, T.; Desvaux, M.; Tragoolpua, Y. Antioxidants of fruit extracts as antimicrobial agents against pathogenic bacteria. Antioxidants 2022, 11, 602. [Google Scholar] [CrossRef] [PubMed]
- Pavanello, E.P.; Brackmann, A.; Simão, D.G.; de Oliveira, J.M.S.; Both, V.; Wendt, L.M.; Sorrenti, G.; de Paula, B.V.; Toselli, M.; Brunetto, G. Effect of foliar-applied silicon sources on brown rot (Monilinia fructicola). Crop Prot. 2022, 156, 105928. [Google Scholar] [CrossRef]
- Massi, F.; Torriani, S.F.; Borghi, L.; Toffolatti, S.L. Fungicide resistance evolution and detection in plant pathogens: Plasmopara viticola as a case study. Microorganisms 2021, 9, 119. [Google Scholar] [CrossRef]
- George, A.S.; Brandl, M.T. Plant bioactive compounds as an intrinsic and sustainable tool to enhance the microbial safety of crops. Microorganisms 2021, 9, 2485. [Google Scholar] [CrossRef]
- Fisher, M.C.; Hawkins, N.J.; Sanglard, D.; Gurr, S.J. Worldwide emergence of resistance to antifungal drugs challenges human health and food security. Science 2018, 360, 739–742. [Google Scholar] [CrossRef]
- Mann, A.; Nehra, K.; Rana, J.S.; Dahiya, T. Antibiotic resistance in agriculture: Perspectives on upcoming strategies to overcome upsurge in resistance. Curr. Res. Microb. Sci. 2021, 2, 100030. [Google Scholar] [CrossRef]
- Thakur, M.; Sohal, B.S. Role of elicitors in inducing resistance in plants against pathogen infection: A Review. Int. Sch. Res. Not. 2013, 2013, 762412. [Google Scholar] [CrossRef] [PubMed]
- Romanazzi, G.; Feliziani, E.; Sivakumar, D. Chitosan, a biopolymer with triple action on postharvest decay of fruit and vegetables: Eliciting, antimicrobial and film-forming properties. Front. Microbiol. 2018, 9, 2745. [Google Scholar] [CrossRef] [PubMed]
- Betchem, G.; Johnson, N.A.N.; Wang, Y. The application of chitosan in the control of post-harvest diseases: A review. J. Plant Dis. Prot. 2019, 126, 495–507. [Google Scholar] [CrossRef]
- Tian, B.; Cheng, J.; Zhang, T.; Liu, Y.; Chen, D. Multifunctional chitosan-based film loaded with hops β-acids: Preparation, characterization, controlled release, and antibacterial mechanism. Food Hydrocoll. 2021, 124, 107337. [Google Scholar] [CrossRef]
- Žabka, M.; Pavela, R. The dominance of chitosan hydrochloride over modern natural agents or basic substances in efficacy against Phytophthora infestans, and its safety for the non-target model species Eisenia fetida. Horticulturae 2021, 7, 366. [Google Scholar] [CrossRef]
- Romanazzi, G.; Mancini, V.; Foglia, R.; Marcolini, D.; Kavari, M.; Piancatelli, S. Use of chitosan and other natural compounds alone or in different strategies with copper hydroxide for control of grapevine downy mildew. Plant Dis. 2021, 105, 3261–3268. [Google Scholar] [CrossRef] [PubMed]
- Román-Doval, R.; Torres-Arellanes, S.P.; Tenorio-Barajas, A.Y.; Gómez-Sánchez, A.; Valencia-Lazcano, A.A. Chitosan: Properties and its application in agriculture in context of molecular weight. Polymers 2023, 15, 2867. [Google Scholar] [CrossRef]
- Rajestary, R.; Landi, L.; Romanazzi, G. Chitosan and postharvest decay of fresh fruit: Meta-analysis of disease control and antimicrobial and eliciting activities. Compr. Rev. Food Sci. Food Saf. 2021, 20, 563–582. [Google Scholar] [CrossRef]
- EUR-Lex. Available online: https://eur-lex.europa.eu/legal-content/EN/TXT/?uri=celex%3A32014R0563 (accessed on 23 October 2023).
- Cabrera, J.C.; Boland, A.; Cambier, P.; Frettinger, P.; Van Cutsem, P. Chitosan oligosaccharides modulate the supramolecular conformation and the biological activity of oligogalacturonides in Arabidopsis. Glycobiology 2010, 20, 775–786. [Google Scholar] [CrossRef]
- van Aubel, G.; Buonatesta, R.; Van Cutsem, P. COS-OGA: A novel oligosaccharidic elicitor that protects grapes and cucumbers against powdery mildew. Crop Prot. 2014, 65, 129–137. [Google Scholar] [CrossRef]
- van Aubel, G.; Cambier, P.; Dieu, M.; Van Cutsem, P. Plant immunity induced by the COS-OGA elicitor is a cumulative process that involves salicylic acid. Plant Sci. 2016, 247, 60–70. [Google Scholar] [CrossRef] [PubMed]
- Moreau, S.; van Aubel, G.; Janky, R.S.; Van Cutsem, P. Chloroplast electron chain, ROS production, and redox homeostasis are modulated by COS-OGA elicitation in tomato (Solanum lycopersicum) leaves. Front. Plant Sci. 2020, 11, 1920. [Google Scholar] [CrossRef] [PubMed]
- Clinckemaillie, A.; Decroës, A.; van Aubel, G.; Carrola dos Santos, S.; Renard, M.E.; Van Cutsem, P.; Legrève, A. The novel elicitor COS-OGA enhances potato resistance to late blight. Plant Pathol. 2017, 66, 818–825. [Google Scholar] [CrossRef]
- EUR-Lex. Available online: https://eur-lex.europa.eu/legal-content/EN/TXT/?uri=CELEX%3A32015R0543 (accessed on 19 December 2021).
- European Commission. EGTOP Final Report on Plant Protection (III). Available online: https://www.organic-farming.europa.eu (accessed on 20 December 2021).
- Moumni, M.; Romanazzi, G.; Najar, B.; Pistelli, L.; Ben Amara, H.; Mezrioui, K.; Karous, O.; Chaieb, I.; Allagui, M.B. Antifungal activity and chemical composition of seven essential oils to control the main seedborne fungi of cucurbits. Antibiotics 2021, 10, 104. [Google Scholar] [CrossRef] [PubMed]
- Huang, J.; Jiang, H.; Qiu, M.; Geng, X.; Yang, R.; Li, J.; Zhang, C. Antibacterial activity evaluation of quaternary chitin against Escherichia coli and Staphylococcus aureus. Int. J. Biol. Macromol. 2013, 52, 85–91. [Google Scholar] [CrossRef] [PubMed]
- Hu, Y.; Zhang, J.; Yu, C.; Li, Q.; Dong, F.; Wang, G.; Guo, Z. Synthesis, characterization, and antioxidant properties of novel inulin derivatives with amino-pyridine group. Int. J. Biol. Macromol. 2014, 70, 44–49. [Google Scholar] [CrossRef]
- Alessandri, S.; Mancino, O.; Grimaldi, A.; Melillo, M.; Fanelli, A.; Cavazza, F.; Bellingeri, G.; Pasqualini, E. COS-OGA: Experiences on powdery mildew control on table grape, wine grape and strawberry. In Proceedings of the Atti, Giornate Fitopatologiche, Chianciano Terme, SI, Italy, 6–9 March 2018; Volume 2, pp. 403–410. [Google Scholar]
- Sui, Y.; Ma, Z.; Meng, X. Proteomic analysis of the inhibitory effect of oligochitosan on the fungal pathogen, Botrytis cinerea. J. Sci. Food Agric. 2019, 99, 2622–2628. [Google Scholar] [CrossRef]
- Song, Y.S.; Seo, D.J.; Jung, W.J. Characterization and antifungal activity of chitosanase produced by Pedobacter sp. PR-M6. Microb. Pathog. 2019, 129, 277–283. [Google Scholar] [CrossRef]
- Ke, C.L.; Deng, F.S.; Chuang, C.Y.; Lin, C.H. Antimicrobial actions and applications of chitosan. Polymers 2021, 13, 904. [Google Scholar] [CrossRef]
- Molina-Hernandez, J.B.; Landi, L.; Laika De Fraviis, R.; Romanazzi, G.; Chaves-López, C. Understanding the mechanisms of action of atmospheric cold plasma towards the mitigation of the stress induced in molds: The case of Aspergillus chevalieri. Innov. Food Sci. Emerg. Technol. 2023, 90, 103492. [Google Scholar] [CrossRef]
- De Miccolis Angelini, R.M.; Landi, L.; Raguseo, C.; Pollastro, S.; Faretra, F.; Romanazzi, G. Tracking of diversity and evolution in the brown rot fungi Monilinia fructicola, Monilinia fructigena, and Monilinia laxa. Front. Microbiol. 2022, 13, 854852. [Google Scholar] [CrossRef] [PubMed]
- Villarino, M.; Melgarejo, P.; De Cal, A. Growth and aggressiveness factors affecting Monilinia spp. survival peaches. Int. J. Food Microbiol. 2016, 227, 6–12. [Google Scholar] [CrossRef] [PubMed]
- Yang, L.Y.; Zhang, J.L.; Bassett, C.L.; Meng, X.H. Difference between chitosan and oligochitosan in the growth of Monilinia fructicola and control of brown rot in peach fruit. LWT—Food Sci. Technol. 2012, 46, 254–259. [Google Scholar] [CrossRef]
- Ma, Z.; Yang, L.; Yan, H.; Kennedy, J.F.; Meng, X. Chitosan and oligochitosan enhance the resistance of peach fruit to brown rot. Carbohydr. Polym. 2013, 94, 272–277. [Google Scholar] [CrossRef] [PubMed]
- Ali, A.; Muhammad, M.T.M.; Sijam, K.; Siddiqui, Y. Potential of chitosan coating in delaying the postharvest anthracnose (Colletotrichum gloeosporioides Penz.) of Eksotika II papaya. Int. J. Food Sci. Technol. 2010, 45, 2134–2140. [Google Scholar] [CrossRef]
- Cely-Veloza, W.; Yamaguchi, L.; Quiroga, D.; Kato, M.J.; Coy-Barrera, E. Antifungal activity against Fusarium oxysporum of quinolizidines isolated from three controlled-growth Genisteae plants: Structure-activity relationship implications. Nat. Prod. Bioprospect. 2023, 13, 9. [Google Scholar] [CrossRef]
- Tikhonov, V.E.; Stepnova, E.A.; Babak, V.G.; Yamskov, I.A.; Palma-Guerrero, J.; Jansson, H.B.; Lopez-Llorca, L.V.; Salinas, J.; Gerasimenko, D.V.; Avdienko, I.D.; et al. Bactericidal and antifungal activities of low molecular weight chitosan and its N-/2 (3)-(dodec-2-enyl) succinoyl/-derivatives. Carbohydr. Polym. 2006, 64, 66–72. [Google Scholar] [CrossRef]
- Tsai, G.J.; Su, W.H. Antibacterial activity of shrimp chitosan against Escherichia coli. J. Food Prot. 1999, 62, 239–243. [Google Scholar] [CrossRef]
- Mirbagheri, V.S.; Alishahi, A.; Ahmadian, G.; Petroudi, S.H.H.; Ojagh, S.M.; Romanazzi, G. Toward understanding the antibacterial mechanism of chitosan: Experimental approach and in silico analysis. Food Hydrocoll. 2024, 147, 109382. [Google Scholar] [CrossRef]
- European Commission. EU Pesticides Database (v.2.2) Active Substance. Available online: https://ec.europa.eu/food/plant/pesticides/eu-pesticides-database/active-substances/index.cfm?event=as.details&as_id=1193 (accessed on 21 December 2021).
- European Food Safety Authority. Conclusion on the Peer Review of the Pesticide Risk Assessment of the Active Substance COS-OGA. Available online: https://www.efsa.europa.eu/en/efsajournal/pub/3868 (accessed on 20 December 2021).
- Wan, A.; Xu, Q.; Sun, Y.; Li, H. Antioxidant activity of high molecular weight chitosan and N, O-quaternized chitosans. J. Agric. Food Chem. 2013, 61, 6921–6928. [Google Scholar] [CrossRef]
- Du, D.X.; Vuong, B.X. Study on preparation of water-soluble chitosan with varying molecular weights and its antioxidant activity. Adv. Mater. Sci. Eng. 2019, 2019, 8781013. [Google Scholar] [CrossRef]
- Prabu, K.; Natarajan, E. In vitro antimicrobial and antioxidant activity of chitosan isolated from Podophthalmus vigil. J. Appl. Pharm. Sci. 2012, 2, 75. [Google Scholar] [CrossRef]
- Romanazzi, G.; Moumni, M. Chitosan and other edible coatings to extend shelf life, manage postharvest decay, and reduce loss and waste of fresh fruits and vegetables. Curr. Opin. Biotechnol. 2022, 78, 102834. [Google Scholar] [CrossRef] [PubMed]
Disclaimer/Publisher’s Note: The statements, opinions and data contained in all publications are solely those of the individual author(s) and contributor(s) and not of MDPI and/or the editor(s). MDPI and/or the editor(s) disclaim responsibility for any injury to people or property resulting from any ideas, methods, instructions or products referred to in the content. |
© 2023 by the authors. Licensee MDPI, Basel, Switzerland. This article is an open access article distributed under the terms and conditions of the Creative Commons Attribution (CC BY) license (https://creativecommons.org/licenses/by/4.0/).